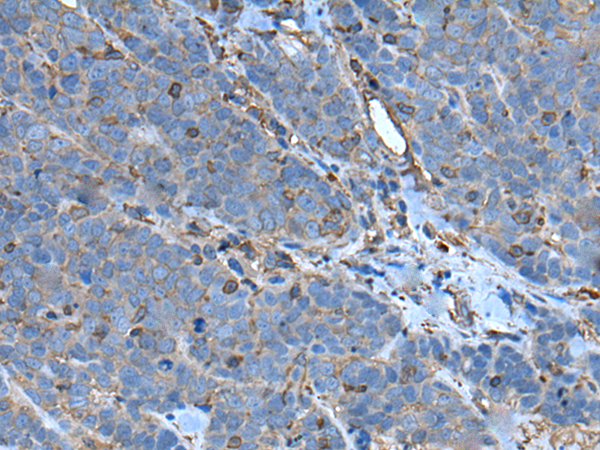

-
分类: 科研抗体货号: P05233别名: RNF35应用: IHC反应种属: Human
-
分类: 科研抗体货号: P05259别名: RPSKA; NY-CO-10; SDCCAG10; SDCCAG-10应用: WB,IHC反应种属: Human, Mouse, Rat
-
分类: 科研抗体货号: P05284别名: SAF2; SIGLEC-8; SIGLEC8L应用: WB,IHC反应种属: Human
-
分类: 科研抗体货号: P05232别名: BERP; HAC1; RNF22; RNF97应用: WB,IHC反应种属: Human, Mouse, Rat
-
分类: 科研抗体货号: P05257别名: SCP2; SCP-2应用: IHC反应种属: Human, Mouse, Rat
-
分类: 科研抗体货号: P05282别名: SLG2; PRO940; SIGLEC-10应用: WB,IHC反应种属: Human
-
分类: 科研抗体货号: P05297别名: NCLX; NCKX6; SLC24A6应用: WB,IHC反应种属: Human, Mouse, Rat
-
分类: 科研抗体货号: P05256别名: CT8; SCP1; SCP-1; HOM-TES-14应用: IHC反应种属: Human
-
分类: 科研抗体货号: P05270别名: SSP1; SUSP1应用: WB,IHC反应种属: Human
-
分类: 科研抗体货号: P05296别名: JSX; OCA6; NCKX5; SHEP4应用: IHC反应种属: Human

鄂公网安备42018502007531号
鄂公网安备42018502007531号

